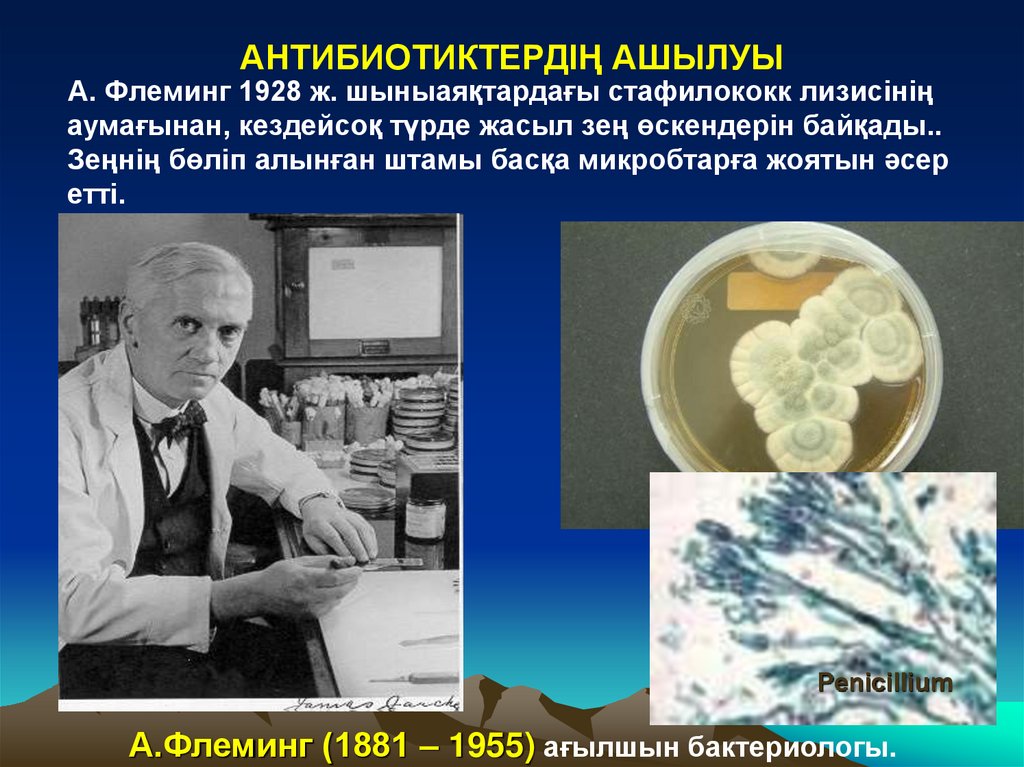
АНТИБИОТИКТЕРДІҢ АШЫЛУЫ

Похожие презентации:
ПӘН «Микробиология»
1. Алматы технологиялық университети Тағамдық биотехнология кафедрасы ПӘН «Микробиология» Дәріскер: Алибаева Бахыт Насихатқызы
2.
Дәріс № 1Тақырыбы:
«Кіріспе»
Жоспары
1. Микробиология ғылым ретінде қалыптасуы.
Микробиологияның зерттеу нысандары. Мақсаты мен
міндеттері
2. Микробиологияның түрлері.
3. Микробиология дамуының тарихи кезендері
4. Тағам өндіріснің микробиологиясы.
5. Микроорганизмдердің жалпы қасиеттері.
6. Медициналық микробиология.
7. Бақылау сұрақтар.
3.
• БАКТЕРИИ - ең көне организмдер пайда болған шамамен 3,5млрд. жыл бұрын (архейде).
• МИКРОБИОЛОГИЯ (грек сөзі «micros» - кіші, «bios» тіршілік, «logos» - ғылым) - өздерінің микроскопиялық
пішініне байланысты микроорганизмдер (микробтар) деп
аталатын, оптикалық құралмен қарамаса жай көзге
көрінбейтін организмдерді зерттейтін ғылым саласы.
Жалпы микробиологияның негізгі бөлімдері
Цитология
Морфология
Генетика
Систематика
Микроорганизмдердің көбею
Микроорганизмдердің биохимиясы
Микроорганизмдердің экологиясы
4. Пәннін мақсаты және міндеттер:
• Мақсаты: микроорганизмдердің және олардың қоршаған ортадағырөлін, ішкі ұйымдастыру, микроорганизмдердің метаболизм, азық-түлік
өнімдерінің микробиологиясын, атап айтқанда, ет және ет өнімдері,
балық және балық өнімдерін микробиологиясын, осы өнімдерге
қойылатын санитарлық-гигиеналық талаптарды қалыптастыруды
үйрету болып табылады; тамақ аурулары мен тағамдық улануды
туғызатын патогенді микроорганизмдермен танысу, микробтық
бүлінуге байланысты азық-түлік қауіпсіздігін мен тұтастығын сақтау
маманының рөлін түсіндіру болып табылады.
• Міндеттері: -микро-организмдер мен жұмыс істеу әдістерін білу;микроорганизмдердің барлық топтарының морфологиясымен таныстыру;
-Микроорганизмдердің физиологиясы және биохимиясына түсінік беру,
сондай-ақ олардың тіршілік ету қабілетіне қоршаған орта
факторларының әсерлері туралы түсінік беру;
• -Ет және балық өнімдерінің микробиология сын үйрету;
-Зертханалық зерттеулерде микробиологиялық көрсеткіштерге
байланысты тамақ өнімдерінің қауіпсіздігін бақылау әдістерін үйрету.
5. Микроорганизмдер
• Микроорганизмдер табиғатта кең тараған және кез-келгенсубстраттарда,
тіпті күрделі құрылысты жануарлар және
өсімдіктер
организмдерінде
тіршілік
етуге
қабілетті.
Микроорганизмдер барлық климат белдеулерінде,
барлық
жерлерде, адам организмінде де тіршілік етеді. Микробиология
микроорганизмдердің
морфологиясын,
олардың
даму
заңдылықтары мен тіршілік ету ортасында тудыратын
процесстерін, сонымен қатар адамзат тіршілігі мен табиғаттағы
ролін зерттейді. Микроорганизмдердің белгілі бір қоректік ортаға
ұзақ уақыт аралығында бейімделуі, микроәлемнің әртүрлі класс
өкілдерінің спецификалық белсенділігін тудырады. Олар өлген
жануарлар мен өсімдіктер қалдықтарын ыдыратып, қоршаған
ортаны
қорғауға
атсалысады.
Микроорганизмдердің
өміршеңдігінен пайдалы қазбалардың түзілуі,
топырақтың
құнарлылығы, су қоймаларының өздігінен тазалануы, т.с.с
байланысты. Микроорганизмдердің пайдалы қасиеттері көптеген
тағам өнімдерінің,
әртірлі биологиялық белсенді заттар
(ферменттер, амин қышқылдары, витаминдер, антибиотиктер
және т.б) өндірісінің технологияларында қолданылады.
6. Микроорганизмдер
Микроорганизмдер
Микроорганизмдердің ішінде ерекше топ бар – патогенді
(ауру тудырушы) микроорганизмдер. Ондай микроорганизмдер
адам ағзасына тағаммен бірге түсіп, тағамдық инфекциялық
аурулар
тудыруы
мүмкін.
Бактериялардың
шамасын
микрометр мен ( 1 мм = 1000 мкм ) өлшейді. Бактериялардың
органелларың мөлшерің нанометрде (1 мкм = 1000 нм)
білдіреді. Электрондық микроскопия пайдалану кезінде өте
ұсақ өлшем – ангстремы ( 1 мм = 10000000 А ) ретінде
білдіреді.
Микроорганизмдер арасында клеткалық құрылымы жоқ,
басқа микроорганизмдерден химиялық құрамы бойынша
ерекшеленетін топ: вирустар және бактериофагтар. Тірі
организмдер жүйесіндегі вирустар мен фагтардың күйі әлі
күнге дейін мәлім емес. Вирустар клеткаішілік паразиттер бола
отырып, адам, жануар, және өсімдіктердің әртүрлі ауруларын
тудырады. Бактериофагтар бактериялар клеткаларында
паразиттік түрде тіршілік етіп,
пайдалы микрофлораны
қолдануға негізделген: тағам өндірісі, биологиялық белсенді
заттар
(антибиотиктер,
бактериалды
ферменттер)
өндірістеріне зиян келтіреді.
7. МИКРОБИОЛОГИЯНЫҢ құрылымы
ЖалпыМорфология
(микробтардың
құрылымы)
Микробтардың
физиологиясы
Микробтардың
биохимиясы
Микробтардың
генетикасы
Микробтардың
экологиясы
Микробтардың
эволюциясы
Жеке
Медициналық
бактериология;
вирусология;
микология;
протозоология;
санитарлық микробиология;
Ветеринарлық
Ауыл шаруашылықтық
Санитарлық және тағамдық
микробиология
Теңіздік
Ғарыштық
Техникалық (биотехнология)
7
25.09.2025
8.
ТүрлеріМИКРОБИОЛОГИЯ
ЖАЛПЫ
ЖЕКЕ
медициналық
ветеринарлық
техникалық
Тағамдық
Теориялық
зерттеулер
Практикадағы
мәні
Ауыл
шаруашылықтық
Микроорганизмдердің биологиялық қасиеттерін зерттеу
Әдістерді өңдеу
профилактикасын,
диагностикасын
және санитарлық
бақлау
Әдістерді
өңдеу
профилакти
касын,
диагностика
сын және
жануарлард
ы емдеу
Нәтижесі:
1.Ашыту өнімдері
(спирттер және
т.б.)
2.ақуыздар
3.витаминдер
4.антибиотиктер
Топырақтың
өнім беру
қабілетінің
жоғарылауы.
Әдістерді өңдеу
профилактикас
ын,
диагностикасын
,өсімдіктердің
8
ауруларын
25.09.2025
емдеу
9. Микробиологияның арнайы тараулары:
Жалпы микробиология - микробтардыңдамуын,табиғаттағы рөлін зерттейді.
Медициналық микробиология - зерттеу нысаны: патогенді
және шартты патогенді микроорганизмдер, олардың профилактикасы
(алдын алу) және инфекциялық ауруларды этиотропты емдеу.
Ветеринариялық микробиология - зерттеу нысаны:
жануарларда ауру тудыратын микроорганизмдерді зерттейді, оларды
биологиялық диагностикалау, алдын алу және этиотропты емдеу, яғни
ауырған жануарлардың организмінен микроб-қоздырушыны жоюға
бағытталған.
Ауылшаруашылық микробиология- - зерттеу нысаны: зат
алмасуға, тыңайтқыштар дайындауға қолданылатын, өсімдіктердің
ауруын тудыратын және т.б микроорганизмдерді зерттейді.
Санитарлық және тағамдық микробиология-санитарлық
нормативтерді құрастыру, тағам өнімдері мен қоршаған орта
объектілерінің санитарлық жағдайы.
Микроорганизмдер экологиясы
10. МИКРОАҒЗАЛАРДЫҢ МӘНІ
химиялық элементтер көпшілігінің айналымға қатысуы.
топырақтүзудің негізгі факторы.
Көптеген тағам өнімдерін, қышқылдарды, кейбір дәрумендерді,
ферменттер қатарын, антибиотиктерді, дәрілік препараттарды,
ферменттер мен аминқышқылдарын алу.
Қоршаған ортаны әртүрлі табиғи және антропогенді
ластағыштардан тазарту.
Генетикалық инженерияның классикалық нысандары
Кейбірлері адамда, жануарлар мен өсімдіктерде ауыр
сырқаттар тудырады.
11.
эмпирикалықморфологиялық
Заманау
Молекулалыгенетикалық
Микробиологияның
кезеңдері
физиологиялық
иммунологиялық
Антибиотиктердің
ашылу
12. МИКРОБИОЛОГИЯ ДАМУЫНЫҢ ТАРИХИ САТЫЛАРЫ:
1. Морфологиялық кезең.2. Физиологиялық кезең.
3. Заманауи молекулалық-генетикалық кезең.
13.
1675 жылыАнтони ван Левенгук –
микроәлемді алғаш рет
ашты.
Ол 150—300 есе үлкейтетін,
екіжақты ісінген линзаларды
даярлай алды.
Левенгук өзі анықтаған
микроскопиялық тірі
ағзаларды «өте ұсақ
жануарлар» деп санады және
оларға қарапайым
жануарларға тән құрылыс
ерекшеліктері мен
тәртіптерді сәйкес деп
санады.
14.
Антон вам Левенгук (1632-1723)«Микроскоп» А. Ван Левенгука.
15.
Левенгук салған сүреттемелері –микроорганизмдардың формалары:
А - шар тәрізді
В - тізбек тәрізді
Е - диплокок тәрізді
G - спираль тәрізді
F – таяқша тәрізді
білдіреді
16. ФИЗИОЛОГИЯЛЫҚ КЕЗЕҢ - микробиологияның алтын ғасыры (XVII- XIX-ғасырлар аралығы)
Луи Пастер (1822—1895)«Микробтар – табиғатта
үздіксіз ірі рөл ойнайтын,
үздіксіз ұсақ ағзалар».
- өндірістік микробиологияның дамуы,
- табиғаттағы зат айналымындағы микроағзалардың рөлін анықтау,
-анаэробты микроағзалардың ашылуы,
-Асептика ұстанымдарын, стерилдеу әдістерін жасап шығару,
- микроағзалар вируленттілігінің әлсіреуі (аттенуациясы) мен жеке алғанда
қараталақ қарасан, құтыруға қарсы вакциналарды (вакциналық штаммдарды)
алу.
- бактериялардың таза мәдениеттерін алу,
- қараталақ қарасанның, тырысқақтың, құтырудың, тауық тырысқағының
және т.б. аурулардың қоздырғыштарын зерттеу.
17.
Mycobacteriumtuberculosis
Генрих Герман Роберт Кох (1843 – 1910)
-Қатты қоректік орталарда таза мәдениеттерді бөліп алу әдісі (Петри
шыныаяғын қолданысқа енгізді)
- бактерияларды анилин бояуларымен бояу тәсілдері,
- қараталақ қарасан, тырысқақ, туберкулез қоздырғыштарын ашты
- Микроскопия техникасын жетілдіру .
-Хенле- Кох постулаттарды эксперименталды дәлелдеу (триада).
• ауру қоздырғышы науқаста тұрақты анықталуы тиіс
• ол таза мәдениет түрінде бөліп алынуы тиіс
• алынған микроағза, тәжірибе жүргізіліп жатқан жануарларда, сырқат
адамның симптомдарын туғызуы тиіс
Туберкулёз зерттеулері үшін 1905 жылы физиология мен медицинадан
Нобель сыйлығын иеленді.
18.
ОРЫСМИКРОБИОЛОГТАРЫ
Ценковский Л. С.
(1802-1887)
орыс ботанигі, протозоолог
пен бактериолог,төменгі
өсімдіктер мен төменгі
жануарларды зерттеудегі
онтогенетикалық әдістің негізін
қалаушылардың бірі, өсімдік
және жануар әлемінің
генетикалық бірлігі туралы
көзқарасты дамытты.
19.
Виноградский С.Н.(1856 – 1953)
Орыс микробиологы, эколог, топырақ
танушы, микроағзалар экологиясы
мен топырақ микробиологиясының
негізін салушы.
Гамалея Н. Ф.
(1859 – 1949)
кеңес уақытының орыс микробиологғалымы, эпидемиолог, дәрігер.
20.
Габричевский Г. Н.(1860—1907)
орыс ғалым -микробиолог,
эпидемиолог, отандық
бактериологиялық ғылым мен
білім берудің
ұйымдастырушысы.
Омелянский В. Л.
(1867 – 1928)
кеңес уақытының орыс
микробиологы. Негізгі еңбектері
зат (көміртегі мен азот)
айналымындағы микробтардың
рөлін зерттеуге арналған.
21. ИММУНОЛОГИЯЛЫҚ КЕЗЕҢ
Э. Дженнер (1729 – 1923)1796 ж. адамдарға сиыр шешегін егу табиғи
шешекке қарсы тұрақтылықты
тудыратындығын дәлелдеді.
И.И.Мечников (1845—1916)
“микробиология ақыны” (Эмиль Ру),
фагоцитоз теориясын жасады және
иммунитеттің жасушалық теориясын
дәлелдеді.
22.
1892 ж. Ресей ғылым академисының отырысында Д.И.Ивановский, темекініңтеңбілді сырқатының қоздырушысы фильтреленетін вирус екендігін
хабарлады . Бұл күнді вирусологияның туған күні деп, Д.И.Ивановскийді –
оның негізін қалаушы деп санауға болады.
а
я
Д. И. Ивановский (1863—1920)
23. АНТИБИОТИКТЕРДІҢ АШЫЛУЫ
А. Флеминг 1928 ж. шыныаяқтардағы стафилококк лизисініңаумағынан, кездейсоқ түрде жасыл зең өскендерін байқады..
Зеңнің бөліп алынған штамы басқа микробтарға жоятын әсер
етті.
Рenicillium
А.Флеминг (1881 – 1955) ағылшын бактериологы.
24. ЗАМАНАУИ МОЛЕКУЛАЛЫҚ- ГЕНЕТИКАЛЫҚ КЕЗЕҢ
Генетика мен молекулалық биология жетістіктері,
электронндық микроскоптың құрастырылуы.
Тұқым қуалаушылық белгілерінің берудегі ДНҚ рөлінің дәлелі.
Молекулалық-биологиялық және генетикалық зерттеулердің
нысандары ретінде бактериялар, вирустар мен плазмидтерді
пайдалану
25. Тағам өндіріснің микробиологиясы. :
Тағам өндіріснің микробиологиясы.• Тағам өндірісінің микробиологиясы
техникалық (өндірістік)
:
микробиологияға
жатады;
ол
микроорганизмдерді
пайдаланып, әртүрлі тағам өнімдерін: шарап, сыра, нан,
спирт, сүтқышқылды өнімдер, сыр, ашытылған көкөністер
және т.б өндіру әдістерін зерттейді. Тағам өндірісінің
микробиологиясы тағам өндірісіне кері әсерін тигізетін
микроорганизмдердің физиологиясын да зерттейді. Тағам
өнімдерін өндіру және тасымалдау кезінде алдын ала
шаралар қолданып, осы микроорганизмдердің тіршілігін
тежеуге болады.
• Қоршаған
ортаның
әртүрлі
объектілерінен
микроорганизмдердің таза культураларын бөліп алу,
олардың селлекциясы,
өнімділігі жоғары мутагенді
штаммдарды алу, микроорганизмдерді культивирлеудің
негізгі
параметрлерін
қолайландыру
пайдалы
микрофлораның өміршеңдігіне негізделген технологиялық
процесстердің қарқындылығын арттыруға мүмкіндік береді.
26.
Тағам өндіріснің микробиологиясы.• Техникалық пайдалы микроорганизмдердің белсенділігін
арттыру- өз кезеңіндезиянды микрофлораның тіршілігін
тежейді және тағам өнімерінің сапасын жақсартады.
• Тағам өндірісі микробиологиясының негізгі мақсаттарының
бірі тұтынушылар денсаулығына қауіпсіз тағам өнімдерін
өндіру болып табылады. Ол үшін тағам өнімдерінің әртүрлі
топтарының микробиологиялық қауіпсіздік критерийлерін
білу және санитарлы-эпидемиологиялық ережелер мен
нормативтерге сәйкес микробиологиялық бақылау жүргізу
керек.
27. Тағам өндіріснің микробиологиясы.
• Микроорганизмдердіңқасиеттерін
зерттеу
арқасында қалдықсыз технологиялық процесстерді
құрастыру мүмкін болды. Ол процесстердің негізінде:
қалдықтарды қайта өңдеу немесе өндірістің келесі
кезеңдерінде
қолдану
жатады.
Осылайша
микробиология көмегімен қоршаған ортаны қорғау
мәселелері оңтайлы шешіледі.
• Қазіргі кезде көптеген тағам өндірсінің ірі
тармақтарының микробиологиялық зертханалары,
ғылыми-зерттеу
институттары
жұмыс
істейді.
Микробиологиялық зертханалар тағам өндірісі
орындарында шикізат пен дайын өнім сапасын
бақылап отырады.
28. Микроорганизмдердің жалпы қасиеттері.
● Көлемінің кіші болуы (микроорганизмдердің көлемі мкмөлшенеді, 1мкм=1-6м)
Зат
алмасу
процесінің
жылдам
жүруі.
Себебі
микроорганизмдер бүкіл денесімен зат алмасуға қатысады.
Бактерия клеткалары ең кіші болғандықтан олар басқа
микроорганизмдермен салыстырғанда тез өсіп-көбейеді,
одан кейінгі орынды ашытқылар мен саңырауқұлақтар
алады. Өз кезегінде микроорганизмдердегі зат алмасу
процесстері
жануарлармен
салыстырғанда
ондаған,
жүздеген есе жылдам жүреді. Мысалы: салмағы 500кг бұқа
ағзасында 24 сағат ішінде 0, 5кг белок түзілсе, осы уақыт
ішінде 500кг ашытқы 50 000кг нан аса белок синтездеуге
қабілетті.
● Табиғатта кең таралуы. Микроорганизмдердің кіші көлемі
экология
үшін
маңызды
болып
табылады.
Микроорганизмдер ауа ағымы арқылы таралып, барлық
жерде кездеседі.
29. МЕДИЦИНАЛЫҚ МИКРОБИОЛОГИЯ
• Медициналық микробиология келесідей бактериология,вирусология, микология, иммунология, протозоология болып
ажыратылады .
• Медициналық микробиология адамның инфекциялық
ауруларының қоздырғыштарын, олардың морфологиясы,
физиологиясы, экологиясын, биологиялық және генетикалық
сипаттамаларын зерттейді, оларды баптау мен
идентификациялаудың әдістерін, оларды диагностикалаудың,
емдеу мен алдын алудың арнайы әдістерін жасап шығарады.
30.
МИКРОБИОЛОГИЯЛЫҚ ДИАГНОСТИКА ӘДІСТЕРІ:1. Микроскопиялық әдіс.
2. Микробиологиялық (бактериологиялық) әдіс.
3. Биологиялық әдіс.
4. Иммунологиялық әдіс.
- серологиялық,
- аллергологиялық
5. Молекулалық-генетикалық әдіс.
31. МИКРОБИОЛОГИЯЛЫҚ (БАКТЕРИОЛОГИЯЛЫҚ) ӘДІС
микробиологиялық диагностиканың
«алтын стандарты»,
микробиологиялық зерттеулердің
нәтижелері зерттеліп жатқан
материалда қоздырғыштың болуын
нақты анықтауға мүмкіндік береді.
Таза мәдениеттер
идентификациясын микроағзаның
түріне дейін жүргізеді.
32. БАҚЫЛАУ ТАПСЫРМАЛАРЫ
• Сәйкестікті анықтау.Ғалымның микробиологияға тигізген үлесін атаңыз:
Ғалымдар: 1) А. Левенгук; 2) И. Мечников; 3) Д. Ивановский; 4) Р.
Кох; 5) Л. Пастер;
Үлесі : а) фагоцитоз құбылысын ашты; б) микроскоп астында
микроағзаларды көрді; в) вирустарды ашты; г) туберкулез,
тырысқақ қоздырғыштарын бөліп алды; д) құтыруға қарсы
вакцина даярлады.
Мәтінді толықтырыңыз: «Медициналық микробиология …..
зерттейді»
Мәтінді толықтырыңыз : «Микробиологиялық диагностиканың
негізгі әдісі ….. Болып табылады»
33. Бақылау сұрақтар. :
• Микробиология пәні нені оқытады?• Тағам өндіріс орындары микробиологиясының негізгі мақсаты
қандай?
• Тағамдық микробиологияның зерттеу объектілерін атаңыз.
• Микроорганизмдердің негізгі қасиеттері қандай?
• Микробиологияның даму кезеңдерін сипаттаңыз.
• Микробиологияның морфологиялық даму кезеңіне сипаттама
беріңіз.
• Луи Пастердің жаңалықтарына сипаттама беріңіз.
• Қазіргі кезде микробиологияның қандай бөлімдері бар?
• Неміс ғалымы Роберт Кох микробиология дамуына қандай
үлес қосқан?
• Вирусологияның негізін қалаушы кім?
• Заманауи микробиологияның даму перспективалары қандай?
34. Дәрістің басты терминдері:
1. Микроорганизм2. Жалпы микробиология
3. Техникалық микробиология
4. Медициналық микробиология
5 Ветеринарлық микробиология
6. Санитарлық микробиология
7. Тағамдық микробиология
8. Патогендық микроорганизмдер
9. Бактериология;
10. Вирусология;
11. Микология;
12. Протозоология;
35. Әдебиеттер мен электронды ресурстар:
Негізгі:Емцев Е.Т. Микробиология / Е.Т. Емцев, Е.Н. Мишустин. - М.: Дрофа,
2008. - 445 с.
Жарикова Г.Г. Микробиология продовольственных товаров. Санитария и
гигиена / Г.Г. Жарикова. – М.: Академия, 2008. – 300 с.
Толысбаев Б.Т., Бияшев К.Б., Мыктыбаева Р.Ж. Ветеринариялық
санитариялық микробиология/ Алматы, 2008.
Абсатиров Ғ., Боранбаева Т. Ветеринариялық микробиология /Астана:
Фолиант, 2012.
Қосымша:
Хожамуратова С., Әлимарданова М., Әбдікалиева Б. Ет
микробиологиясы./Оқу құралы.- Астана: Фолиант, 2012.-204
В.В.Лысяк Микробиология: учебное пособие //-Минск: БГУ,2007.- 429 с
Жвирблянская А.Ю., Бакушинская О.А. Микробиология в пищевой
промышленности - М.,1975.- 494 с.
Нецепляев С.В. Лабораторный практикум по микробиологии пищевых
продуктов животного происхождения. – М.,1990. – 190с.
http://dic.academic.ru/ Словари и энциклопедии на Академике
www.medmicrob.ru – база данных по общей микробиологии.
www.micro-biology.ru – электронный ресурс по микробиологии для студентов.

Биология
Биология








